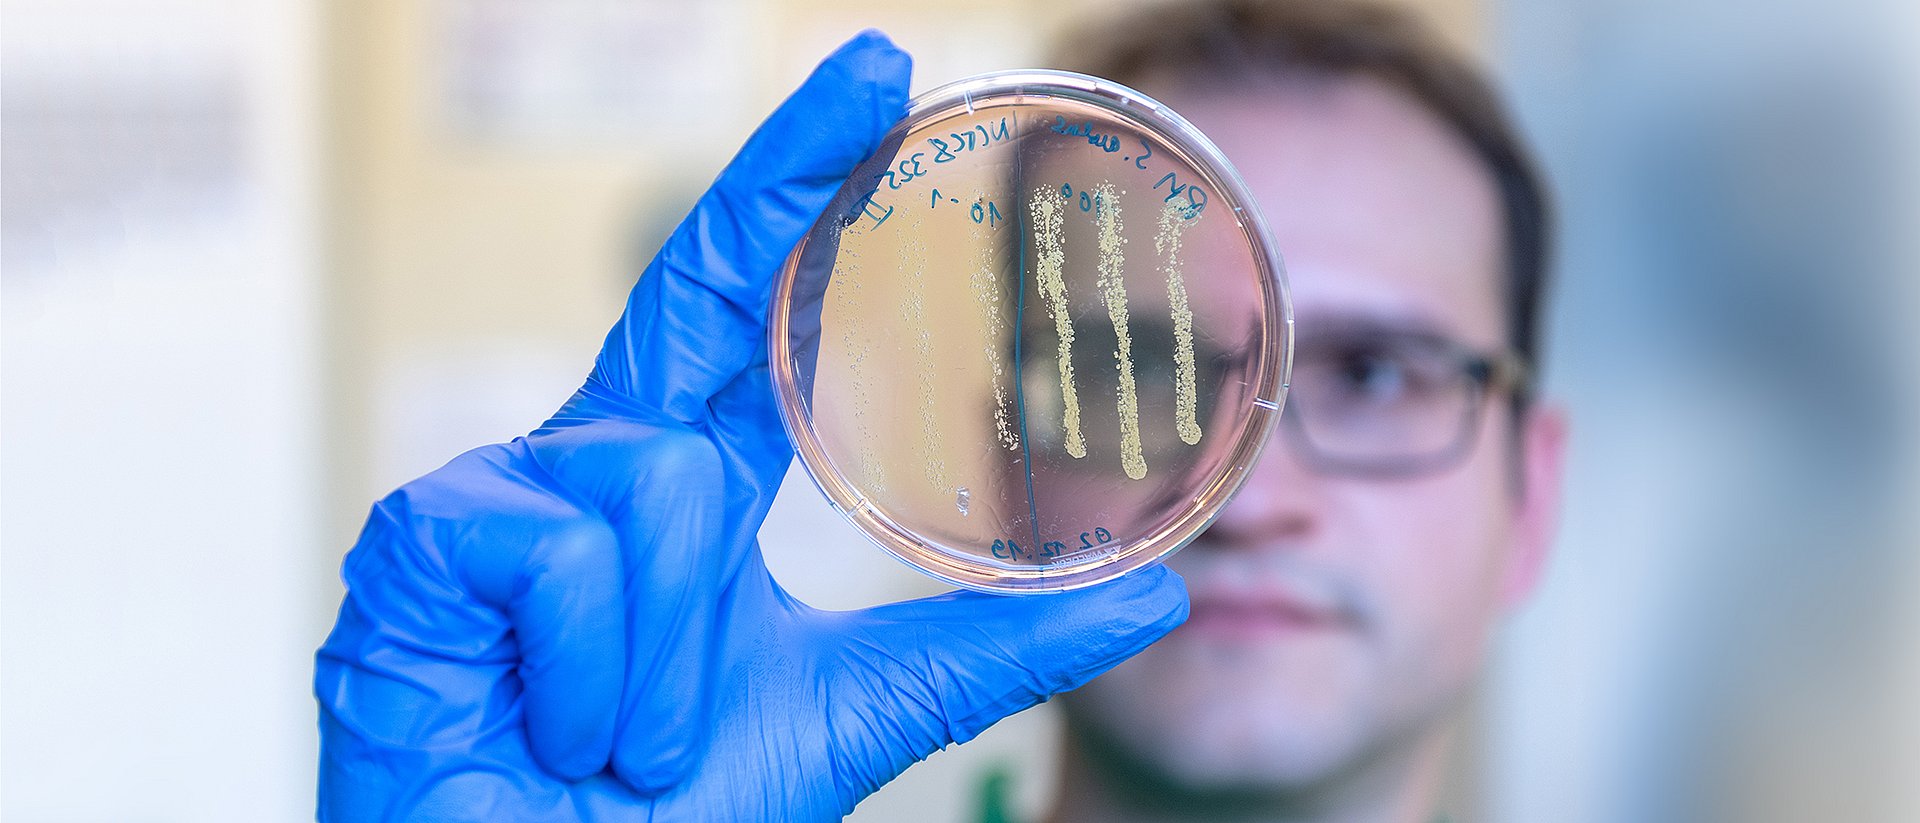
Doktorand Robert Macsics beim Betrachten einer Agar-Platte, auf der Kolonien des Bakteriums Staphylokokkus aureus gewachsen sind. Der Farbwechsel der Platte von Rot zu Gelb im Bereich der Bakterienkolonien zeigt an, dass es sich um Bakterien der Art S. aureus handelt.

Modifizierter Krebs-Wirkstoff wirkt gegen multiresistente Bakterien
Vom Krebsmedikament zum Antibiotikum
Der Methicillin-resistente Staphylococcus aureus (MRSA) ist immer wieder Ursache für schwere und hartnäckige Infektionen. Manche Stämme sind sogar bereits gegen mehrere Antibiotika resistent. Daher werden dringend neue Wirkstoffe benötigt, die MRSA-Infektionen kontrollieren können.
„Die industrielle Entwicklung neuer Antibiotika stockt momentan und hält mit der Ausbreitung von Antibiotikaresistenzen nicht Schritt. Wir brauchen dringend innovative Ansätze, um den Bedarf an neuen Infektionstherapien, die nicht unmittelbar zu erneuter Resistenzbildung führen, zu decken“, sagt Prof. Eva Medina, Leiterin der HZI-Forschungsgruppe Infektionsimmunologie.
Neue Strategien zur Entwicklung von Antibiotika
Eine vielversprechende Strategie ist es, zugelassene Medikamente auf eine mögliche Wirkung gegen Bakterien zu testen. „Unser Schwerpunkt lag hierbei auf einer Klasse von menschlichen Proteinen, sogenannten Kinasen, für die es bereits sehr viele Hemmstoffe gibt“, sagt Studienleiter Prof. Stephan Sieber, Professor für organische Chemie an der TUM.
Der Wirkstoff Sorafenib, ein Krebsmedikament, das gegen MRSA aktiv ist, wurde von ihnen daher chemisch modifiziert, um eine stärkere antibiotische Wirkung zu erreichen. So entwickelten sie das Molekül PK150, das zehnmal wirksamer gegen MRSA ist als die Ausgangssubstanz.
Mehrfachangriff vermeidet Resistenzbildung
Der potente neue Wirkstoff wirkt gegen mehrere unkonventionelle Zielstrukturen bei den Bakterien. Zwei Angriffsziele wurden genauer untersucht: PK150 hemmt einerseits ein essenzielles Protein des bakteriellen Energiestoffwechsels und wirkt andererseits an der Zellwand.
Im Unterschied zu bereits bekannten Antibiotika wie Penicillin und Methicillin, die die Bildung der Zellwand stören, wirkt PK150 indirekt: Es bringt die Proteinproduktion der Bakterien aus dem Gleichgewicht. Dadurch geben die Bakterien mehr Proteine, die die Zellwandstärke kontrollieren, nach außen ab, und die Zellen platzen auf.
In Mäusen war PK150 in verschiedenen Geweben gegen MRSA wirksam. Während Staphylokokken schnell Resistenzen gegen andere Antibiotika entwickeln, beobachteten die Forscher keine Resistenzbildung gegen PK150.
Wirkung gegen Biofilme und Persister-Zellen
Eva Medina und Dr. Katharina Rox, Pharmakologin aus der Abteilung „Chemische Biologie“ am HZI, zeigten, dass PK150 günstige pharmakologische Eigenschaften aufweist. Es kann beispielsweise als Tablette verabreicht werden und ist im Körper über mehrere Stunden stabil. „Durch die chemischen Veränderungen an dem Molekül bindet PK150 auch nicht mehr an die menschlichen Kinasen, sondern wirkt sehr spezifisch gegen bakterielle Ziele“, sagt Sieber.
Und noch ein Plus besitzt PK 150: „MRSA-Infektionen sind besonders häufig chronisch, da die Bakterien in eine Art Ruhezustand verfallen können. PK150 tötet auch diese sowie Keime, die sich geschützt in Biofilmen befinden“, sagt Prof. Dietmar Pieper, Leiter der HZI-Forschungsgruppe „Mikrobielle Interaktionen und Prozesse“.
Im Projekt aBACTER optimiert nun die Arbeitsgruppe von Prof. Sieber PK150 weiter, um als nächstes in die klinische Entwicklungsphase eintreten zu können.

Repurposing human kinase inhibitors to create an antibiotic active against drug-resistant Staphylococcus aureus, persisters and biofilms
Philipp Le, Elena Kunold, Robert Macsics, Katharina Rox, Megan C. Jennings, Ilke M. Ugur, Maria Reinecke, Diego Chaves-Moreno, Mathias W. Hackl, Christian Fetzer, Franziska A. M. Mandl, Johannes Lehmann, Vadim S. Korotkov, Stephan M. Hacker, Bernhard Kuster, Iris Antes, Dietmar Pieper, Manfred Rohde, William M. Wuest, Eva Medina, Stephan A. Sieber
Nature Chemistry, 16.12.2019 – DOI: 10.1038/s41557-019-0378-7
Gefördert wurden die Arbeiten durch die Europäische Gemeinschaft (durch das European Research Council (ERC) und im Rahmen des Forschungsprogramms CHEMMINE), die Deutsche Forschungsgemeinschaft (im Rahmen des Exzellenzclusters Center for Integrated Protein Science Munich (CIPSM) und des Sonderforschungsbereichs SFB 1035), durch den Fonds der Chemischen Industrie, den Boehringer Ingelheim Fonds, das Deutsche Zentrum für Infektionsforschung (DZIF), die National Science Foundation (NSF) und das National Institute of General Medical Sciences (beide USA). Das Projekt aBACTER wird vom Bundesministerium für Bildung und Forschung (BMBF) im Rahmen des Programms VIP+ gefördert.
Beteiligt waren neben dem Lehrstuhl für Organische Chemie, dem Lehrstuhl für Proteomik und Bioanalytik und der Radiochemie München der TUM verschiedenen Arbeitsgruppen des Helmholtz-Zentrums für Infektionsforschung, das Deutsche Zentrum für Infektionsforschung, das Deutsche Krebsforschungszentrum (DKFZ), die Temple University (Philadelphia, USA) und die Emory University (Atlanta, USA). Stephan Sieber ist außerdem wissenschaftlich assoziiert mit dem Helmholtz-Institut für Pharmazeutische Forschung Saarland (HIPS), einem Standort des HZI in Kooperation mit der Universität des Saarlands sowie mit dem Institute for Advanced Study der TUM.
Technische Universität München
Corporate Communications Center
- Dr. Andreas Battenberg
- battenberg@zv.tum.de
- presse@tum.de
- Teamwebsite
Kontakte zum Artikel:
Prof. Dr. Stephan A. Sieber
Technische Universität München
Lehrstuhl für Organische Chemie II
Lichtenbergstr. 4, 85748 Garching
Tel.: +49 89 289 13302
stephan.sieber@tum.de





